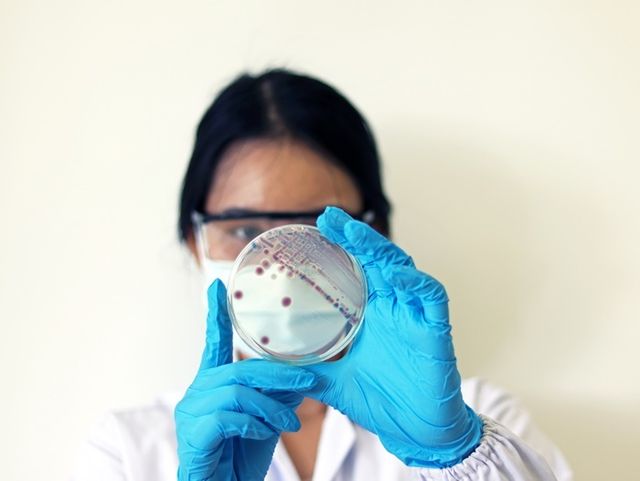

몸에 치명적인 세균이 국내에서 올해 처음으로 발견됐다.
지난 22일 전북특별자치도 보건환경연구원에 따르면 지난 14일 해수에서 채취한 해수에서 비브리오패혈증균이 검출됐다.
바닷물의 온도가 상승하면 빠르게 증식하는 비브리오 불니피쿠스(Vibrio vulnificus) 균에 의해 발생하는 이 질환은, 해산물을 즐기는 이들에게는 특히 위험하다. 일반적인 식중독과는 다르게 증상이 급격하고 치명률이 매우 높아, 한 번 감염되면 생명을 잃을 수도 있다.
 기사의 이해를 돕기 위한 사진 / Light Win-shutterstock.com
기사의 이해를 돕기 위한 사진 / Light Win-shutterstock.com
비브리오패혈증은 이 균에 오염된 어패류, 특히 생선회나 조개류 등을 날로 섭취하거나, 상처가 있는 피부가 오염된 바닷물에 접촉할 경우 감염될 수 있다. 감염 후 잠복기는 보통 12시간에서 72시간이며, 발열과 오한, 복통, 구토 등의 전신 증상과 함께 피부에는 괴사성 병변이 생길 수 있다. 이 병변은 통증을 동반하며 급속히 진행되며, 심할 경우 피부와 근육이 괴사해 사지 절단이나 사망으로 이어지기도 한다.
특히 간 질환자, 당뇨병 환자, 면역력이 약한 사람은 비브리오패혈증에 감염될 위험이 높고, 치명률 또한 일반인보다 훨씬 크다. 국내에서 보고된 비브리오패혈증 치사율은 평균 약 50%에 이른다. 질병관리청에 따르면 매년 6월부터 10월 사이, 특히 8~9월에 집중적으로 발생하며, 대부분 남성 환자들이고 50세 이상의 중장년층이 많다. 이는 주로 이 연령대에서 생선회를 선호하고, 만성질환을 가지고 있는 경우가 많기 때문이다.
감염 예방을 위해서는 무엇보다 생식 해산물 섭취를 주의해야 한다. 생선회, 조개, 굴 등은 반드시 신선한 것을 선택하고, 가능한 한 익혀 먹는 것이 안전하다. 특히 만성질환이 있는 사람은 여름철에는 날것의 해산물 섭취를 피하는 것이 바람직하다. 조리를 할 경우에도 중심 온도가 85도 이상에서 1분 이상 유지되도록 충분히 가열해야 한다.
기사의 이해를 돕기 위한 사진 / Arpon Pongkasetkam-shutterstock.com
기사의 이해를 돕기 위한 사진 / Arpon Pongkasetkam-shutterstock.com
또한 피부에 상처가 있을 경우 바닷물 접촉을 피하고, 해수욕이나 어패류 손질 후에는 반드시 손과 피부를 깨끗이 씻는 것이 중요하다. 낚시나 갯벌 체험 후 상처 부위에 붉은 반점이나 부종이 생기면 즉시 병원을 방문해야 한다. 감염 초기에 항생제 치료가 시작되면 회복 가능성이 높지만, 시간이 지체되면 빠르게 패혈증으로 진행될 수 있기 때문이다.
비브리오패혈증은 여름철 기온 상승과 함께 점차 국내 발생률이 증가하고 있으며, 지구 온난화로 인해 위도 상 북쪽 해안까지 감염 가능 지역이 확대되고 있다는 우려도 있다. 바다의 선물인 해산물, 그 풍미를 안전하게 즐기기 위해서는 위생 수칙을 철저히 지키고, 고위험군이라면 음식을 날것 그대로 먹는 건 삼가해야 한다.
Copyright ⓒ 위키트리 무단 전재 및 재배포 금지
본 콘텐츠는 뉴스픽 파트너스에서 공유된 콘텐츠입니다.



